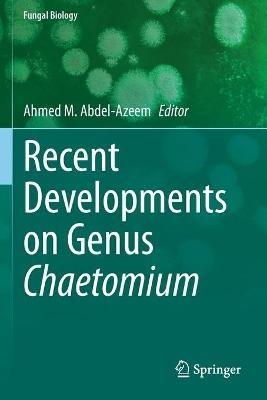
Recent Developments on Genus Chaetomium - cover

L’articolo è stato aggiunto alla lista dei desideri
IBS.it, l'altro eCommerce
Recent Developments on Genus Chaetomium
Cliccando su “Conferma” dichiari che il contenuto da te inserito è conforme alle Condizioni Generali d’Uso del Sito ed alle Linee Guida sui Contenuti Vietati. Puoi rileggere e modificare e successivamente confermare il tuo contenuto. Tra poche ore lo troverai online (in caso contrario verifica la conformità del contenuto alle policy del Sito).
Grazie per la tua recensione!
Tra poche ore la vedrai online (in caso contrario verifica la conformità del testo alle nostre linee guida). Dopo la pubblicazione per te +4 punti
Altre offerte vendute e spedite dai nostri venditori



Tutti i formati ed edizioni
Promo attive (1)
Chaetomium genus was established by Gustav Kunze in 1817. According to Index Fungorum Partnership, there are 273 Chaetomium species accepted till now. Members of the genus Chaetomium are capable of colonizing various substrates and are well-known for their ability to degrade cellulose and to produce a variety of bioactive metabolites. More than 200 compounds have been reported from this genus. A huge number of new and bioactive secondary metabolites associated with unique and diverse structural types, such as chaetoglobosins, epipolythiodioxopiperazines, azaphilones, depsidones, xanthones, anthraquinones, chromones, and steroids, have been isolated and identified. Many of the compounds have been reported to possess significant biological activities, such as antitumor, antimalarial, cytotoxic, enzyme inhibitory, antimicrobial, phytotoxic, antirheumatoid and other activities. Chaetomium taxa are frequently reported to be cellulase and ligninase producers withthe ability to degrade cellulosic and woody materials. This is the first, comprehensive volume covering Chaetomium genus in detail. It includes the latest research, methods, and applications, and was written by scholars working directly in the field. The book also contains informative illustrations and is fully referenced for further reading.
L'articolo è stato aggiunto al carrello
Le schede prodotto sono aggiornate in conformità al Regolamento UE 988/2023. Laddove ci fossero taluni dati non disponibili per ragioni indipendenti da IBS, vi informiamo che stiamo compiendo ogni ragionevole sforzo per inserirli. Vi invitiamo a controllare periodicamente il sito www.ibs.it per eventuali novità e aggiornamenti.
Per le vendite di prodotti da terze parti, ciascun venditore si assume la piena e diretta responsabilità per la commercializzazione del prodotto e per la sua conformità al Regolamento UE 988/2023, nonché alle normative nazionali ed europee vigenti.
Per informazioni sulla sicurezza dei prodotti, contattare productsafetyibs@feltrinelli.it
L’articolo è stato aggiunto alla lista dei desideri